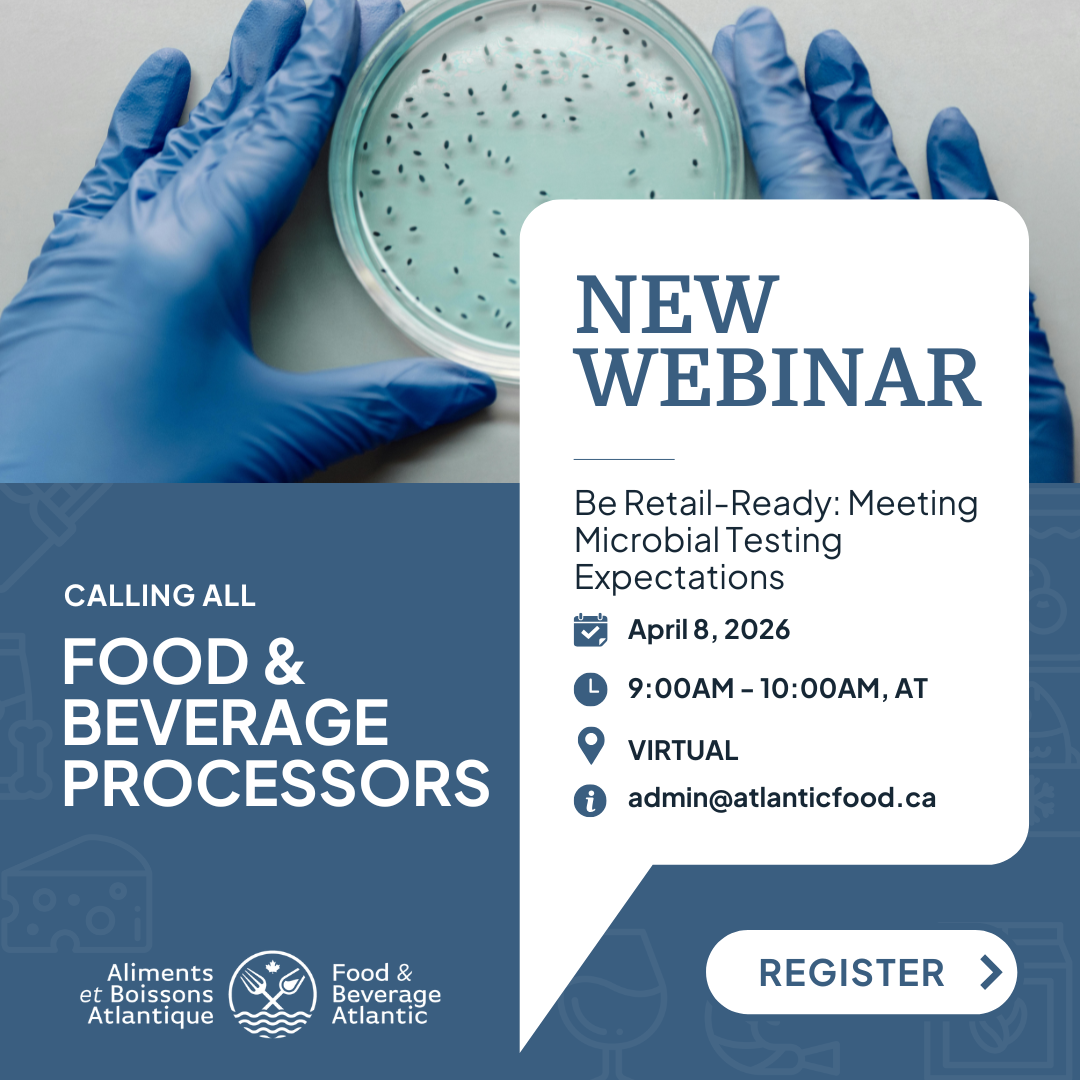

Loading…

Tags
Select the Use button to add a tag to the body of your email. You may also use tags in the subject of your email by copying and pasting them directly in.
| {FIRST_NAME} | Adds the recipients First Name. | Use |
| {LAST_NAME} | Adds the recipients Last Name. | Use |
| {COMPANY_NAME} | Adds the Company Name. | Use |
| {PORTAL_NAME} | Adds the application portals name. | Use |
| {MEMBER_NAME} | Adds the Recipients Membership name. | Use |
| {SIGNATURE_OPT_IN} | Adds the Opt-in link. | Use |
| {SIGNATURE_OPT_OUT} | Add the opt-out link. | Use |
| %signature% | Adds your preferred signature block. | Use |
| {Event_Start_Date} | Adds the Event's Start Date.(Events Only) | Use |
| {Event_End_Date} | Adds the Event's End Date.(Events Only) | Use |
| {Event_Name} | Adds the Event's Name.(Events Only) | Use |
| {Event_Description} | Adds the Event's Description.(Events Only) | Use |
| {Online_Training_Description} | Adds the Online Training Description.(Online Training Only) | Use |
| {Event_Specific_Dates} | Adds the Event's specific dates.(Events Only) | Use |
| {member_number} | Adds the Membership Number. | Use |
| {MemberSince} | Adds the Member Since Date. | Use |
| {CONTACTEMAIL} | Adds the organization email address used as the "From" address for other membership-related emails (e.g., new member welcome emails). Manage email addresses here. | Use |
| {EVENT_CREDITS} | Adds the Event's Credits.(Events Only) | Use |
| {EVENT_CREDITS} | Adds the Event's Credits.(Events Only) | Use |
| {CERTIFICATE_NUMBER} | Adds the Contact's Certificate Number | Use |
| {EVENTLOCATION} | Adds the Event's Location. | Use |
| {TOTALEVENTCREDITS} | The total number of credits that the contact has earned through the event tickets and workshops. | Use |
| {ASAPPEARSONBADGE} | Display the text of as appears field in the event setup. | Use |
| {contact_organization} | Displays the organization name of the contact. | Use |
| {RENEWALDATE} | Adds the Member Renewal Date in (yyyy-mm-dd). | Use |
| {MEMBERSHIP_YEAR} | Adds the Member's Membership Year | Use |
| {RENEWALDATE_MM-DD-YYYY} | Adds the Member Renewal Date in (mm-dd-yyyy). | Use |
| {LMS_CREDIT} | The number of credits the LMS course is worth for Continuing Education | Use |
| {COLLECTION_PERIOD_END-DATE_YYYY_MM_DD} | The end date of the CE collection period end date | Use |
| {LMS_COURSE_COMPLETION_DATE} | The completion date of the LMS course | Use |
| {INCEPTION_DATE} | Adds the Member Inception Date in (yyyy-mm-dd). | Use |
| {EVENT_END-DATE_MONTH_YYYY} | Adds Event End Date in Full Month Name and Year Format.(Events Only) | Use |
| {EVENT_END-DATE_MONTH_YYYY_ADD3} | Adds Event End Date in Full Month Name and Year Format Plus 3 Years.(Events Only) | Use |
| {WORKSHOP_NAME} | Adds the workshop name (if applicable) | Use |
| {WORKSHOP_DESCRIPTION} | Adds the workshop description (if applicable) | Use |
| {WORKSHOP_CREDITS} | Adds the workshop credit for related workshop (if applicable) | Use |
| {TOTALWORKSHOPCREDITS} | Adds the sum of all workshop credits for related event (if applicable) | Use |
| {Event_Start_Date_DD-MM-YYYY} | Adds the Event's Start Date in (dd-mm-yyyy).(Events Only) | Use |
| {Event_End_Date_DD-MM-YYYY} | Adds the Event's End Date in (dd-mm-yyyy).(Events Only) | Use |
| {RENEWALDATE_DD-MM-YYYY} | Adds the Member Renewal Date in (dd-mm-yyyy). | Use |
| {RENEWAL_DATE_MONTH_DD_YYYY} | Adds the Member Renewal Date in (Month Dth, yyyy). | Use |
| {INCEPTIONDATE_DD-MM-YYYY} | Adds the Member Inception Date in (dd-mm-yyyy). | Use |
| {TODAYSDATE} | Adds the current date. | Use |
| {TODAYSYEAR} | Adds the current year. | Use |
| {QR_CODE} | Adds the QR Code for their contactID, name, and emailAddress | Use |
| {WORKSHOP_DATE} | The date of the workshop (if applicable). | Use |
| {WORKSHOP_START_TIME} | The start time of the workshop (if applicable). | Use |
| {WORKSHOP_END_TIME} | The end time of the workshop (if applicable). | Use |
| {MEMBEREMAIL} | Adds the Member's Email Address. | Use |
| {INCEPTIONDATE_DD_MONTH_YYYY} | Adds the Member Inception Date in (Day Month Year). - eg. 27 October 2025 | Use |
| {RENEWAL_DATE_DD_MONTH_YYYY} | Adds the Member Renewal Date in (Day Month Year). - eg. 27 October 2025 | Use |
- A clearer understanding of how environmental monitoring supports retailer and audit confidence
- Insight into how A3 (ATP + ADP + AMP) testing can provide earlier and more sensitive hygiene verification than ATP-only approaches
- Practical ways to combine hygiene verification, rapid pathogen detection, and accredited lab testing within a risk-based monitoring program
- Guidance on using environmental monitoring data to support audit discussions and demonstrate program effectiveness
Personal information:
Personal information is collected on this website only when you voluntarily submit it by, for example, registering for the website, or updating your user profile. We respect the privacy of your personal information. Any collected personal information will not be shared, sold, or disclosed to any person or party, and will only be used within to communicate our news, events, and other services with you.
Information collected from your computer or other electronic device:
We may also collect information about your online activities and your computer or other electronic device when you visit this website. This information may include your Internet Protocol (IP) address, domain name, browser type, date and time of your request and information provided by tracking technologies, such as cookies. This information does not identify any individual. We may also use tracking devices to identify websites that you visit before and after this website. This tracking helps us to understand our users better and to improve our website and the information it provides and to maintain and administer the website. This tracking does not involve the collection of personal information.
Access and choice:
Keeping your information accurate and up-to-date is important so we can provide you with helpful information and services. You may update, correct, or delete personal information by modifying your user profile. You can choose not to receive information about specific products and services, or any other promotional materials, from us by direct mail and/or e-mail at any time by modifying your communication preferences also located in your user profile.
Links to other websites:
We may provide links to third-party websites. We are not responsible for and cannot control the privacy practices of those other sites. Those sites will have their own privacy policy which may be different from this privacy policy. Please check the privacy policy for each site you visit.
Changes to the privacy policy:
We reserve the right to revise this privacy policy at any time. You will be notified of any significant changes made herein.
By completing purchases with us you agree to have your Credit card and personal information securely stored as part of a payment profile within a 3rd party payment gateway. This securely stored payment profile will be used, when authorized, for automated recurring payments and will allow for easier and faster checkouts. No credit card information is stored within Member365 and all payment data is accessed by way of a secure API. Under no circumstances do we share credit card or personal details.
Who can access the Food and Beverage Atlantic Member Portal member portal?
Please note that the Food and Beverage Atlantic Member Portal member portal is to be used by members of Food and Beverage Atlantic Member Portal only. Certain workspaces within the member portal will be tailored for and restricted to certain membership types; access to these areas will be determined and approved by Food and Beverage Atlantic Member Portal staff. The Content that is displayed in your member portal will automatically vary based on your user / membership type.
What can be posted?
To ensure all interactions within the Food and Beverage Atlantic Member Portal member portal are safe and friendly, Food and Beverage Atlantic Member Portal staff will oversee the member portal activity and will review, edit, and delete any inappropriate content that has been submitted. This includes abusive or offensive language, spam, malicious files, or other disrespectful contact. To help provide a productive environment, please report any offensive or suspicious activity to Food and Beverage Atlantic Member Portal staff. Please note that not all user-submitted content is representative of Food and Beverage Atlantic Member Portal, nor does it necessarily represent the views of Food and Beverage Atlantic Member Portal, its staff or members.
